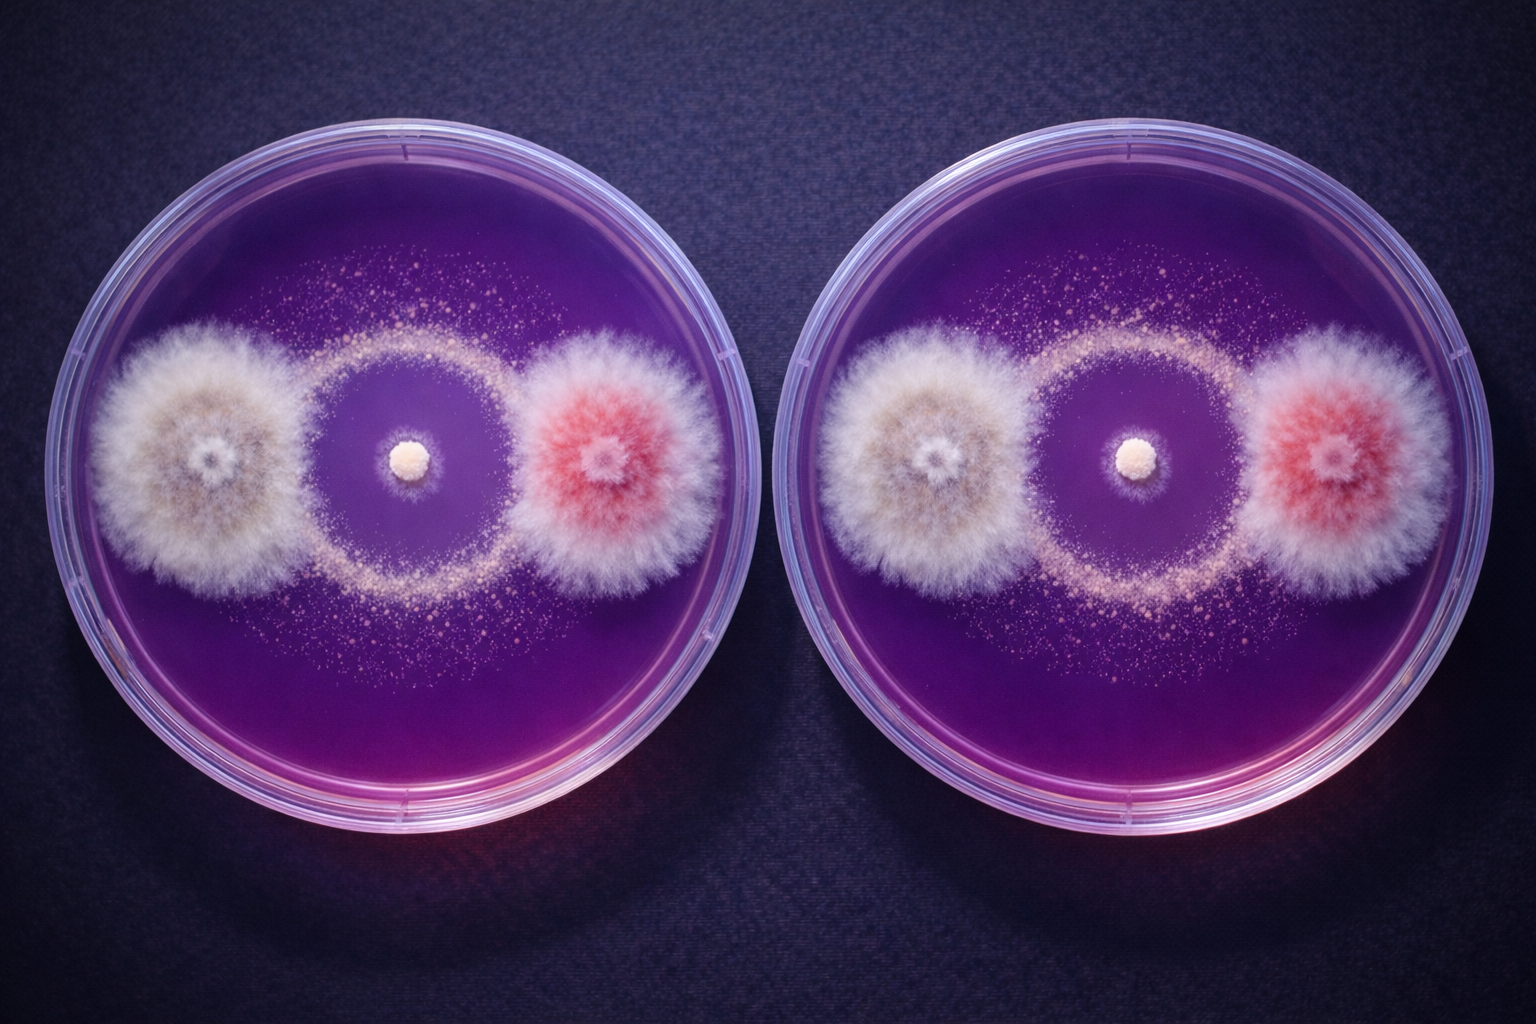

Exacta Bioscience
Chilean startup protecting plants using nature's own predators.
Co-founder & CEO
Case studies about our products and services
Chilean startup protecting plants using nature's own predators.
Co-founder & CEO

A leading research hub of top Chilean universities.
Co-founder & CEO

Chilean start-up dedicated to ensuring food security with biologically derived solutions.
Co-founder & CEO